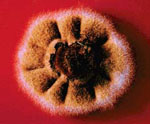

| Glarea lozoyensis 74030 |
[ Opisthokonta | Fungi | Dikarya | . . .
. . . | Helotiaceae | Glarea | Glarea lozoyensis ]
 Picture Source
Picture Source
|
Genome files |
| Glarea lozoyensis 74030 |
[ Opisthokonta | Fungi | Dikarya | . . .
. . . | Helotiaceae | Glarea | Glarea lozoyensis ]
Picture Source
Picture Source
|
Genome files |